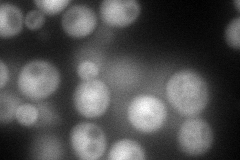
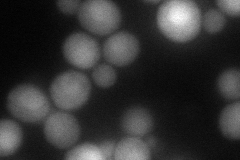
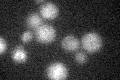

View description
Peripheral membrane protein that is required for vacuolar H+-ATPase (V-ATPase) function, although not an actual component of the V-ATPase complex; functions in the assembly of the V-ATPase; localized to the yeast endoplasmic reticulum (ER)
Localization:
Intensity:
Fold change:
Significance:
-
C’ GFP library in SD

ER19.27 -
N' NOP1pr-GFP in SD
cytosol,nucleus150.268 -
N' TEF2pr-mCherry in SD
cytosol,nucleus100.044 -
N' NATIVEpr-GFP in SD

below threshold16.7702 -
N' TEF2pr-VC and Cyto-VN in SD

cytosol35.3343 -
C’ GFP library in SD+DTT

ER19.311No -
C’ GFP library in SD+H2O2

ER19.581.01No -
C’ GFP library in Starvation Media
ER23.421.21No -
C’ GFP library on the background of Pup2-DaMP

ER -
C’ GFP library on the background of CCT mutant

ER16.14390.837315No
